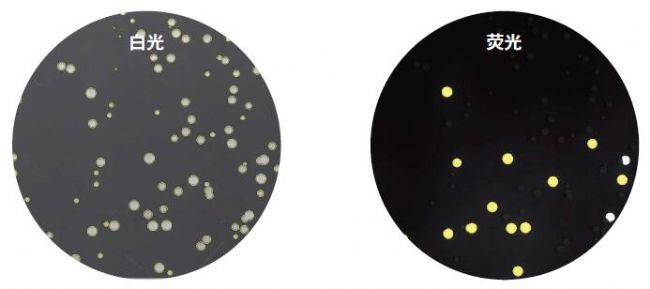
微生物篩選系統

- 美谷分子儀器(上海)有限公司
- 地址:上海市長寧區(qū)福泉北路518號1座501室
- 聯系人:市場部
- 電話:4008203586
- 郵箱:info.china@moldev.com
- 官網:http://www.moleculardevices.com.cn
產品詳情
微生物克隆篩選系統QPix 400
不單單是挑克隆
微生物克隆篩選系統QPix 400給科學家提供的不僅僅是更準確的挑取克隆。硬件和軟件上的升級保證每天能夠準確挑取成千上萬的克隆,并且可以記錄跟蹤涂布、挑取、復制及重排等操作過程。在挑克隆之前,還可以根據熒光信號對克隆進行有目的的、定量性的篩選。
滿足不同應用和不同通量的工作需求
微生物克隆篩選系統QPix 400 是由曾經廣泛應用于人類基因組計劃多家測序中心、成熟出眾的QPix robotics 經過升級發(fā)展后的新型號平臺。仍然適用于常規(guī)的應用如噬菌體展示,合成生物學等。
熒光成像為高效篩選獨特的克隆提供了客觀、定量化的數據
多組熒光波長濾光片可以靈活選擇多樣的熒光克隆載體,獲得所有克隆的客觀和定量的熒光數據。當研究蛋白折疊或分泌、酶進化或蛋白定位的時候,可以追蹤熒光蛋白獲得單個克隆的獨特數據。此外,還可以篩選某種轉化標記或者篩選突變體。


從涂布到挑選. 在成像和挑取克隆之前,QPix™460 可以全自動加樣和涂布 ( 從一塊 96 孔樣品板到QTray 培養(yǎng)板 ),使它成為功能靈活的一個平臺。QPix 460 系統可以用于研究蛋白質工程、蛋白質進化、酶定向進化、蛋白表達以及轉化子和亞克隆庫的管理。

從成像到挑選. QPix™ 450 具有更高容量的終微孔板容量使它更適用于酶進化,克隆管理,庫篩選以及生物燃料的開發(fā)。

全功能的桌面系統. QPix™ 420 系統具有 QPix 400系列的所有應用和性能優(yōu)點,但是體積更小。它非常適合于希望用自動化克隆挑取代替人工挑選的實驗室。
每次都挑到正確的克隆
優(yōu)秀的性能確保數據質量、單克隆和高活性。先進的成像和分析,聯合磁力驅動精確控制的機械臂,避免出現重復挑或者空白孔,降低人工挑選的錯誤以及交叉污染的風險,確保挑到正確的克隆。
儀器特點:
1,優(yōu)良的挑選速度和準確性
2,超聲波瓊脂厚度探測器
3,多種微生物特異性的挑針
4,完全空氣驅動的挑樣頭 ( 24-, 96- 和 384 三種規(guī)格挑頭可選 )
5,專有的鹵素燈挑針干燥過程
6,液體處理能力 ( 僅 QPix 460 )
7,針對不同應用的、獨特的克隆識別軟件算法
8,完整的數據追蹤程序
儀器優(yōu)勢:
1,白光下高達 3000 克隆每小時,熒光下高達 2000 克隆每小時,> 98% 挑選效率,
2,根據檢測到的瓊脂厚度自動校正挑取高度,確保挑取效率高
3,確保成功挑取多種類型的微生物,而不單單是E. Coli ,提高克隆成活率
4,一臺系統可以同時滿足 10 臺測序儀器的克隆數目需求
5,公認的挑針清洗程序避免污染
6,全自動操作流程:從加樣、涂布到挑取
7,通過實驗針對性的參數,簡單地通過軟件操作確保挑到正確的克隆
8,完整的數據追蹤程序記錄數據,并可追蹤樣品的每一步操作:從樣品涂布到挑取,以及復制重排等過程

成像分析軟件在白光下識別單個克隆。根據用戶自定義參數選擇克隆:緊湊性、軸比、大小、鄰近度等。
可選的預篩選提供了克隆獨特的信息,用于識別實驗中更好的克隆。根據用戶自定義參數選擇克隆:緊湊性、軸比、大小、鄰近度以及熒光強度水平等。

針對每個區(qū)域提前定義要挑取克隆的數目。 黃色:根據參數要被挑取的克隆。綠色:達到預先設置的克隆數目。紅色:沒有達到預先設置的克隆數目。
更快獲得結果


加快克隆的客觀性、定量性篩選
快速篩選蛋白表達過程中的載體構建和目的蛋白克隆。
? 預篩選,挑取正確的克隆
? 識別熒光信號強度在某個特定水平的克隆
? 自動化并且追蹤記錄從轉化子涂布 ( 僅 QPix 460 ) 到克隆挑取等整個操作流程

應用于合成生物學自動篩選候選克隆
? 自動成像和選取工程微生物克隆
? 高準確性挑取
? 記錄追蹤所有實驗數據

高效篩選噬菌體展示庫,識別抗體候選克隆
? Automatically select and pick phage-containing E. coli colonies

高效低成本構建 DNA 文庫和克隆管理
使用專用的軟件模塊完成復制、點膜及重排等操作。





